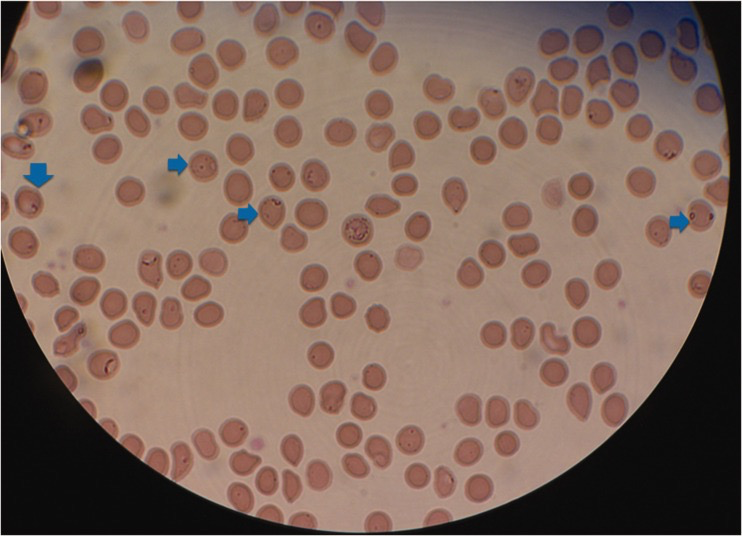

来源:丁香园
本文作者:地猫
细胞装模作样地掸了掸袍袖,吟道:「红鲜雅称金盘饤,软香真堪玉箸挑。」
01
规培轮转到血液科的第一天,我便大受震撼。
一位中年妇女刚办入院时体温 38 度,护士便给了她一个冰袋用于降温,结果一个没看住,病人把冰袋撕开冲水喝了,随即发生呕吐,科室里兵荒马乱。
这个病人该轮到我收,我一进病房便感受到浓郁的红烧肉香气,隔着口罩都差点把我的口水勾下来。看到我过来,她忙把饭盒中的肉和饭几口扒完,正襟危坐地准备好。
患者 37 岁女性,症状有发热、黄疸、寒战、进行性虚弱,体温最高 41 度。在外地县医院诊断为骨髓增生异常综合征,但治疗了半年也没有好转,患者就是为这个来的。
入院时血红蛋白浓度 107 g/L,白细胞 4.9×10^9/L。红细胞沉降率为 51 mm/h,C 反应蛋白水平为 18.4 mg/L,均高于正常值。
问病史时,我再一次受到震撼:「之前吃偏方居然吃了一年多?吃的什么偏方?」
她用一口我勉强能听懂的方言解释着:「就我们老家地里长的草药嘛,吃那个确实有用,吃完就不怎么黄啦。」
患者 2 年前开始小便变黄、巩膜黄染,自己吃了不知什么神奇的植物,黄疸竟真的有所减轻。但这神农草明显治标不治本。
「半年前我开始反反复复的发烧,我去了县医院看,他们开了两种药让我每天吃,结果吃到现在也没见好,还不如我那偏方呢……」患者不满地咕哝着。
当地二级医院的骨髓细胞学检查报告显示,骨髓穿刺涂片中有核红细胞比例明显增多,可见病态造血,可见环形铁幼粒细胞,诊断为骨髓增生异常综合征。
我皱了皱眉,根据中华医学会血液学分会制订的《骨髓增生异常综合征中国诊断与治疗指南(2019 年版)》,骨髓增生异常综合征的诊断必须符合「一系或多系持续性减少(≥6 个月)」和「排除所有其他造血组织或非造血组织疾病」两个条件,此外还需要结合一些辅助条件来诊断,比如流式细胞术检测骨髓细胞表型、基因点突变分析、祖细胞集落形成检测等。
图源:骨髓增生异常综合征中国诊断与治疗指南截图
当地二级医院没有排除其他疾病,也没有进行这些辅助检查,这个诊断有些草率了。但这应该是二级医院的条件限制,一些检测可能无法进行。
翻到下一张检验报告,我的心中翻腾起重重疑虑。肝胆脾 CT 显示肝脾肿大,肝门静脉、下腔静脉扩张,这个表现是骨髓增生异常综合征无法解释的,难不成是误诊?
02
我写病历时敲键盘的手越来越滞涩,最后心事重重地停了下来,妄图理顺思路。
由于对骨髓增生异常综合征的诊断存疑,我觉得应该开一个复查外周血涂片和骨髓细胞学检查、骨髓细胞表型与基因点突变分析的医嘱。
为什么会有门脉扩张?如果肝硬化继发了脾功能亢进,就会破坏红细胞造成贫血,然后顺理成章地产生黄疸,这个过程完美。可是肝硬化从哪来呢?难道有隐匿肝炎史?可以开乙肝五项查一查。
将视线移回到血液系统后,我第一个想到溶血性贫血,血管内溶血和血管外溶血都有可能,可以开 Coombs 试验和 CD55、CD59 检测排查。
我顺着免疫的思路想到了系统性红斑狼疮等结缔组织疾病,可以开抗核抗体、双链 DNA 抗体等免疫抗体谱。
我找到同组的师兄,将自己的思路说了一遍。
师兄看着病历,眉头皱成一团蚯蚓,「嘶」地吸了口气,听得我胆战心惊。
「首先,这个当地二级医院诊断的骨髓增生异常综合征确实有问题。但是我觉着哈,你说的肝硬化继发脾亢可能性也不大。」师兄扁着嘴,苦大仇深地摇了摇头。
「为什么?」我忙虚心求教。
「因为肝硬化的话除了胆红素升高,肝酶也应该升高,但患者肝酶正常。而且脾亢是三系减少嘛,一般首先引起白细胞、血小板减少,然后再出现红细胞减少,但这个患者白细胞和血小板都正常。」师兄又挑眉道:「溶血性贫血和结缔组织病确实应该考虑,但你还落了很重要的一项。患者为什么反复发热?」
我理所当然地说:「应该是有并发感染吧,比如系统性红斑狼疮患者如果有血液系统受累,可能会导致免疫系统受影响。你看患者白细胞 4.9×10^9/L,虽然没低于正常值但也是偏低的,有感染风险。」
师兄慢条斯理地摆手:「我觉得应该尽量用一元论解释,你有没有想过可能就是感染性疾病导致了这一系列的肝大、贫血、黄疸、发热等等?你一会开个感染科会诊吧,估计需要做一个比较全面的感染源筛查。」
我按照师兄的嘱咐开好了各项医嘱和会诊。感染科医生所开的医嘱主要是导致发热和出血的感染源检查,如疟疾、利什曼原虫、登革病毒、伤寒杆菌、布鲁氏菌、钩端螺旋体、巴贝虫。一些常见的导致发热的感染源也没放过,如柯萨奇病毒、EB 病毒、巨细胞病毒、疱疹病毒、结核等。
我觉得万无一失。
03
检查结果出来的时候我傻眼了,甚至内心替师兄也傻眼了一下——所有结果都是阴性的,包括 MDS 基因检测、所有感染源检查、乙肝五项、抗体检查、Coombs 试验等,血涂片也没有新发现。我一无所获。
在等结果的期间,师兄给患者用过阿莫西林、左氧氟沙星、头孢曲松、青蒿素,但这些经验性抗生素治疗完全无效。抗生素治疗后的血液培养呈阴性,但病人还在继续发烧,简直诡异。
我垂头丧气地去换了三个药,回到办公室突然发现气氛变了很多——变香了。
我一阵猛嗅,猪突猛进地奔向香味的源头,师兄兴高采烈地叫我:「那个喝冰袋的病人,她家属给她送饭来了,顺便多带了一饭盒的红烧肉给咱科室的大夫尝尝,说是自家养的猪肉做的。嘿你别说真香!」
红烧肉旁边围了一圈人,用平时攒下的一次性筷子抢肉。我义不容辞地加入了他们的队伍。
图源:图虫创意
我嘶嘶地抽着凉气,将滚热鲜香的肉在腮帮子里翻动着,才把师兄刚才的话过了脑子:「这患者家里养猪的啊?养多久了?」
师兄百忙之中瞥我一眼:「咋了?你也想辞职养猪去?」
我差点被肥油呛死:「我是在想她这病会不会跟养猪有关啊!」
师兄身形一僵,塞满红烧肉的胖脸凝重起来:「你别说,人畜共患病,还真有可能。」
师兄开始拼命赶我:「你快去,问问患者有没有吃过生肉,有没有被动物抓伤咬伤过。」
我誓死捍卫我的肉:「我要吃完再去!」
04
问完病史回来,我的脚步都轻快了很多。患者在我的百般追问下终于回忆起来自己「 2 年前逮猪的时候被猪咬了一口在手上」,跟发病时间正好对上了。
会导致肝大、贫血、黄疸、发热的猪的人畜共患病,我锁定了猪附红细胞体病。
附红细胞体病在我国并不十分罕见,全国各地感染率相差较大,主要集中于农牧区。杭州市疾控中心的调查数据显示,杭州市 580 人中平均感染率为 9.31%,包括控制人员、肉类加工工人、屠宰经营者、兽医和农场工人。
附红细胞体是一种支原体,这种生物粘附在红细胞表面,但不会侵入红细胞,常引起猪的传染性贫血。它还会为宿主细胞提供铁元素,造成大量铁在红细胞内沉积,这也可以解释为什么二级医院的骨髓活检结果会显示存在环形铁粒幼细胞。
附红细胞体的扫描电镜图
图源:参考文献[3]
附红细胞体病的诊断主要依赖于外周血涂片和骨髓细胞涂片,但由于附红细胞体会导致溶血,在常规单细胞薄层的血涂片中很难被发现。如果没有流行病学史支持、检验科医生没有得到临床医生的额外提示的话,涂片检测的时候也很容易忽略掉。
得到师兄的首肯后,我第一时间开了厚血涂片检查,详细备注了附红细胞体病的猜测。第二天,我望眼欲穿地等到了厚血涂片的结果,显示红细胞中存在附红细胞体(Eperythrozoon)。
血涂片检查所示
图源:参考文献[1]
我幸福得几乎晕眩,拿着结果立刻向师兄炫耀。师兄得意地笑成一副小人得志的模样:「多亏我让你去问病史吧?患者这顿红烧肉没白请我们吃!」
附红细胞体对四环素类和氨基糖苷类抗生素敏感。师兄给患者开了 6 周的米诺环素,患者服药 3 天后便不再发烧,6 周后复查血常规显示血红蛋白恢复正常、血涂片显示附红细胞体明显减少,顺利出院。
(策划:z_popeye、gyouza)
本文改编自真实病例 [1]
致谢:本文经 浙江大学医学院附属第二医院 血液内科主任医师 梁赟、首都医科大学附属北京佑安医院感染综合科主任医师 李侗曾 专业审核
【注】
首都医科大学附属北京佑安医院感染综合科主任医师 李侗曾 审核意见:
附红细胞体病患者血常规结果提示有红细胞计数减少、血红蛋白减少,由于附红细胞体病相对少见,而临床上贫血、黄疸是比较常见的症状,贫血和黄疸的可能原因又比较多,需要初步诊断后做好鉴别诊断。
如果找不到其他原因,临床医师在面对贫血患者的时候诊断骨髓增生异常综合征(MDS)是有一定合理性的,根据中华医学会血液学分会制订的《骨髓增生异常综合征中国诊断与治疗指南(2019 年版)》,诊断 MDS 的需要两个必要标准:(1)持续 4 个月一系或多系血细胞减少;(2)排除其他可导致血细胞减少和发育异常的造血及非造血系统疾病。
在这个病例中,患者贫血持续 2 年,符合标准(1),但是未能排除其他可能导致血细胞减少的原因,骨髓穿刺涂片中出现环形铁幼粒细胞也可以由 MDS 引起,属于 MDS 诊断中的一条相关标准,但并不是 MDS 的特有表现,原则上需要排除其他原因的血红蛋白下降,如铁粒幼细胞性贫血等。
从后面就诊情况看,患者的贫血是附红细胞体病导致的,MDS 属于误诊,这也充分证明了 MDS 诊断标准设置的两条必要标准是非常有必要的。
患者最初被误诊可能和当时患者临床表现不典型、医生诊疗经验不足都有关系。当发现按照第一次诊断的疾病治疗效果不明显的时候,及时去分析其他可能的病因,这也是临床上面对复杂疑难病例和少见疾病的常见流程。
题图来源:视觉中国
参考资料:
[1]Junli Zhang, Xiangyun Zhang,Heng Wang,and Zhihui Zhou.First known case of Eperythrozoon endocarditis in China.J Int Med Res. 2020 Feb; 48(2): 0300060519875352.
[2]De-Sheng Huang, corresponding, Peng Guan, Wei Wu, Tie-Feng Shen, He-Ling Liu, Shuang Cao, Hao Zhou.Infection rate of Eperythrozoon spp. in Chinese population: a systematic review and meta-analysis since the first Chinese case reported in 1991.BMC Infect Dis. 2012; 12: 171.
[3]K. Groebel,1 K. Hoelzle,1 M. M. Wittenbrink,1 U. Ziegler,2 and L. E. Hoelzle.Mycoplasma suis Invades Porcine Erythrocytes.Infect Immun. 2009 Feb; 77(2): 576–584.
中国医保,一生守护!维护医保基金安全,人人有责!打击欺诈骗保举报电话:010-89061396,010-89061397;邮箱:jubao@nhsa.gov.cn。